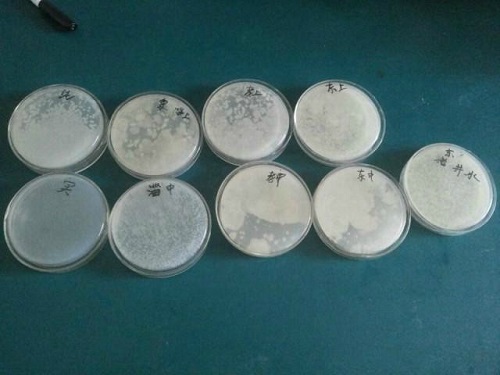

---生命科学公司“烈焰科考队”对淄博南部山区水质的调研
经过一段时间的考察,生命科学公司“烈焰科考队”的队员分别取到了东猪龙河、孝妇河、淄河上游以及中游的水样,由于河流下游有的被大坝拦截,有的道路维修,或接近没水,因此下游水样只能放弃。

为了能够调查更多的水样,考察队在邓洪宽老师的带领下我们赴沂源县调查水样,但到达目的地之后,并没有见到我们所想象的河流,从当地村民那儿了解到由于当地近一整年没有下雨,河流有很多已经干涸,根本找不到水源。已经到达目的地的我们,决定不能轻易放弃,我们用手机GPS导航,步行来到螳螂河附近,地图上的河流显得那么宽,蓄水量那么大,但真正到了之后才发现,几年的时间,河流早已干涸,再没有了以前的波涛汹涌,气势磅礴,剩下的只是河岸两边的石子、砂砾。
取来的水样,在13号楼实验室开始了紧张的实验操作,特别感谢邓洪宽、庞秋香老师、高丽丽师姐等实验室师姐师哥的帮助和支持。在实验室我们测定了不同水系上中游水样的PH值,另外结合专业知识设计实验,检验水样中细菌种类及菌落生长状况,实验过程中大一同学不仅学会了测定PH和无菌操作等基本技术,而且大家在一起相处的这段日子,真正让每一位成员感觉到团结的力量,合作的重要性,以及明确分工的必要性。我相信这段日子,大家一起为共同目标而不断奋斗的时光,将是我们老员工活中浓墨重彩的一笔!感谢那些一直在一起共同奋斗的同学们,你们的奋斗,坚持,努力,支持深深感动和激励着我们为了同一目标不断前进。
经过实验研究调查,淄河中游水质较差,河水呈现黄色,且有较多杂质,PH值严重超标,达到9.44,而生活在其中的细菌呈线状,少数呈单个分布,或许正是这种高碱性水样的缘故,其菌落较为单一,并没有像其他水样呈现不同菌落。其他水质PH值在7--8之间,相对较好,菌落生长状况各不相同,例如孝妇河上游,部分菌落连成片状,个别单一分布,有些菌落相对较小,表面光滑,部分菌落内部可再生出其他菌落,至少三种菌落。而东猪龙河中游菌落较厚,部分连成片状。
经过这次暑假社会实践调研,让我们真正感受到水资源现在面临着严峻的挑战,保护水资源,从一点一滴做起!从我们自身做起,从身边的小事做起,为了我们的天更蓝,山更青,水更绿,行动起来吧!
